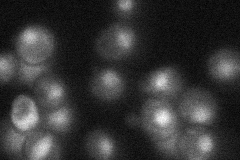
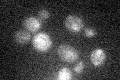

View description
Transcription factor required for derepression of inositol-choline-regulated genes involved in phospholipid synthesis; forms a complex, with Ino2p, that binds the inositol-choline-responsive element through a basic helix-loop-helix domain
Localization:
Intensity:
Fold change:
Significance:
-
C’ GFP library in SD

nucleus26.34 -
N' NOP1pr-GFP in SD

nucleus41.5274 -
N' TEF2pr-mCherry in SD

nucleus7.58664 -
N' NATIVEpr-GFP in SD
nucleus32.1213 -
N' TEF2pr-VC and Cyto-VN in SD

#N/A0 -
C’ GFP library in SD+DTT

nucleus22.820.86No -
C’ GFP library in SD+H2O2

nucleus19.340.73Yes -
C’ GFP library in Starvation Media
nucleus180.68Yes -
C’ GFP library on the background of Pup2-DaMP

nucleus -
C’ GFP library on the background of CCT mutant

nucleus19.58210.743198No
